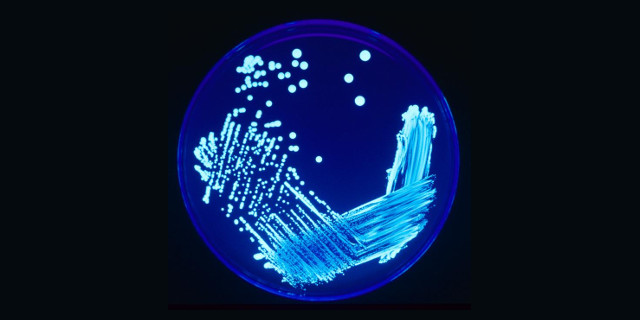

Un caso di legionella a Villa Sofia, verifiche in corso
La scorsa settimana una donna di 63 anni è morta all’ospedale Villa Sofia di Palermo a causa di un’insufficienza respiratoria da polmonite bilaterale da legionella. Sono in corso controlli ai climatizzatori e ai conduttori per l’erogazione idrica e verifiche e campionamenti dell’Asp di Palermo. Continua »

Ultimi commenti (172.603)